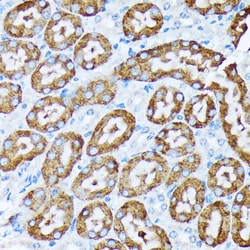
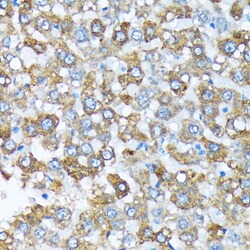

Promotional price valid on web orders only. Your contract pricing may differ. Interested in signing up for a dedicated account number?
Learn More
Learn More
Invitrogen™ CYP4A11/CYP4A22 Recombinant Rabbit Monoclonal Antibody (10D10W7)


Rabbit Recombinant Monoclonal Antibody
Supplier: Invitrogen™ MA537946
Description
Positive Samples: Mouse liver, Rat liver, Rat kidney Immunogen sequence: QFPCPPSHWL FGHIQELQQD QELQRIQKWV ETFPSACPHW LWGGKVRVQL YDPDYMKVIL GRSDPKSHGS YRFLAPWIGY GLLLLNGQTW FQHRRMLTPA F.
This gene encodes a member of the cytochrome P450 superfamily of enzymes. The cytochrome P450 proteins are monooxygenases which catalyze many reactions involved in drug metabolism and synthesis of cholesterol, steroids and other lipids. This protein localizes to the endoplasmic reticulum and hydroxylates medium-chain fatty acids such as laurate and myristate.
Specifications
| CYP4A11/CYP4A22 | |
| Recombinant Monoclonal | |
| 0.6 mg/mL | |
| PBS with 0.05% BSA, 50% glycerol and 0.02% sodium azide; pH 7.3 | |
| P20816, Q02928 | |
| CYP4A11, Cyp4a2 | |
| A synthetic peptide corresponding to a sequence within amino acids 50-150 of human Cytochrome P450 4A (CYP4A11) (CYP4A11) (Q02928). | |
| 100 μL | |
| Primary | |
| Human, Mouse, Rat | |
| Antibody | |
| IgG |
| ELISA, Immunohistochemistry (Paraffin), Western Blot | |
| 10D10W7 | |
| Unconjugated | |
| CYP4A11 | |
| 20-HETE synthase; 20-hydroxyeicosatetraenoic acid synthase; alkane-1 monooxygenase; CP4Y; Cyp4a11; Cyp4a2; Cyp4a-2; CYP4AII; CYPIVA11; CYPIVA2; cytochrome P450 4A11; Cytochrome P450 4A2; cytochrome P450 family 4 subfamily A member 11; cytochrome P-450 K-2; cytochrome P450 K-5; cytochrome P450, family 4, subfamily A, polypeptide 11; cytochrome P450, family 4, subfamily a, polypeptide 2; cytochrome P450, subfamily 4A, polypeptide 11; cytochrome P450, subfamily IVA, polypeptide 11; Cytochrome P-450HK-omega; Cytochrome P450HL-omega; cytochrome P450-LA-omega 2; fatty acid omega-hydroxylase; Lauric acid omega-hydroxylase; long-chain fatty acid omega-monooxygenase; P-450 HK omega; P-450 IV4AII; P-450 K-2; P450 K-5; P450-HL-omega; P450HL-omega; P450-LA-omega 2 | |
| Rabbit | |
| Affinity Chromatography | |
| RUO | |
| 1579, 24306 | |
| -20°C, Avoid Freeze/Thaw Cycles | |
| Liquid |
Product Content Correction
Your input is important to us. Please complete this form to provide feedback related to the content on this product.
Product Title
Spot an opportunity for improvement?Share a Content Correction